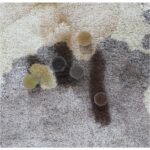
Rugs Dealer in London Dubai

For Bamboo Silk carpets, vacuum regularly using a soft brush attachment to avoid damaging the delicate fibers. Blot spills immediately with a clean, dry cloth and avoid scrubbing to prevent damage. Professional cleaning is recommended to maintain the carpet?s sheen and texture. Keep the carpet dry and away from excessive moisture to prevent water damage, and rotate it periodically to ensure even wear and longevity.

100% Bamboo Silk Handtufted Carpet in Modern style, Brown Color Rug – RC532
د.إ 7,000.00
Enhance your living space with the timeless elegance of our hand-tufted bamboo silk carpet, where artisanal craftsmanship meets eco-friendly luxury.
Out of Stock
Delivery & Return
Ask a Question
20 People viewing this product right now!
Get it today
Free shipping
Free shipping on orders over $75.
30 - Day Returns
Not impressed? Get a refund. You have 30 days to break our hearts.
Dedicated Support
Support from 8:30 AM to 10:00 PM everyday





























Yusuf M. –
The eco-friendly rugs I purchased is stunning and fits perfectly in my study room. Thank you, Enaya Rugs!
Hana Fahad – Ras Al Khaimah, UAE –
I recently purchased a handmade rug from Enaya Rugs, and it has completely transformed my living room! The craftsmanship is unparalleled, and the authentic design adds a touch of elegance to my home. Highly recommend Enaya Rugs for anyone looking for luxury rugs in the UAE!
Adil K. –
Shopping at Enaya Rugs was such a smooth experience. Their Turkish carpets is unmatched in quality.
Laila M. –
The unique carpet designs I purchased is stunning and fits perfectly in my bedroom. Thank you, Enaya Rugs!
Fatima Hussain – Dubai, UAE –
Enaya Rugs offers the finest selection of luxury rugs in Dubai. I purchased a handmade rug, and it has become the centerpiece of my living room. Exceptional quality and service!
Zara Al Mansoori – Abu Dhabi, UAE –
I was looking for a unique piece to complete my home decor, and Enaya Rugs delivered! Their handmade rugs are not just beautiful but also of exceptional quality. It’s a perfect blend of tradition and luxury!
Sarah K. –
Best rugs in the UAE! Enaya Rugs delivered a beautiful antique rugs for my home.
Omar N. –
Thank you, Enaya Rugs, for the high-quality custom rugs! It transformed my living room.
Hassan A. –
I am so happy with the eco-friendly rugs from Enaya Rugs; it’s the best addition to my study room.
Laila M. –
Enaya Rugs offers the best selection of handcrafted rugs in the UAE. Highly recommended!
Rania L. –
The handmade quality of my designer rugs from Enaya Rugs is evident. Perfect for my office.